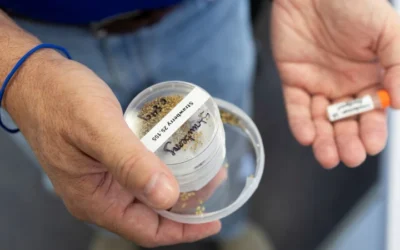
UF Scientists Launch Seeds To Space To Build Climate-Resilient Crops On Earth

Florida scientists to send seeds to ISS to study farming solutions for Earth’s harsh conditions Feature Image: Dr. Wagner Vendrame, professor at the UF/IFAS environmental horticulture department, holds seeds that will be planted as an on-Earth control version of the...
Che Vita Presents The Charm And Cuisine Of Southern Italy At Tampa’s Hilton Downtown
Hilton Tampa Downtown proudly announces the opening of Che Vita, which translates to “what a life” in Italian — a new Southern Italian restaurant designed to elevate the hotel dining experience and bring a fresh culinary identity to the heart of the city. Nestled near...
Turn Up The Heat: Top 10 Flavorful Ways To Enjoy Jalapeños
Stuff ’em. Most of the fiery heat from jalapeños is dissipated when cooked and they develop a mellow, acidic spiciness, which is a perfect partner to cream cheese. Stuff with fat-free cream cheese, chives, and low-fat cheese, then heat on the grill or in the oven and...
Getting Passionate About Passion Fruit
Written by: Brad Buck, Senior Public Relations Specialist, UF/IFASFeature Image: Purple passion fruit. Credit, Tie Liu, UF/IFAS With passion fruit, you get more than just a tasty drink or snack. It’s packed with nutrients like vitamin C, fiber and antioxidants, making...
Grilled Chicken Skewers That Go With Everything: Tacos, Salads, Rice And More
Keep the heat out of your kitchen this summer with these mouthwatering grilled chicken skewers, packed with flavor from a bold, sweet-and-smoky marinade. Made with brown sugar, tomato paste, honey, and a blend of barbecue spices, the sauce adds a tangy kick that...
From Calories To Costs: Landmark Project Redefines Global Food Access
Tufts University researchers measuring the cost of a nutritious diet across the globe are changing how we talk about food security and malnutrition From Tufts Now - Written by Laura Castañón A decade-long project measuring access to healthy foods worldwide is wrapping...
Hydration Hype: Why Regular Water Is Still Your Best Bet
Is One Type of Water Better Than Another? Tufts nutrition experts explain potential advantages to consuming alkaline water, electrolyte water, or other enhanced H20 From Tufts Now - Written by Emily Brognano It’s hot and you’re thirsty, so you pop into a store to up...
New Research Reveals Pandemic’s Unequal Impact On Childhood Obesity Rates
A new nationally representative study published in Annals of Internal Medicine reveals that while overall childhood obesity rates in the United States remained largely unchanged during the COVID-19 pandemic, Black children and adolescents experienced a significant and...
Eat Smart, Spend Less: Easy Food Swaps For Heart-Healthy Living
The AmericanRising food costs can make healthy eating a challenge for many families. In fact, a poll conducted by Research! America found about 60% of Americans cite the cost of healthy food as their single biggest barrier to achieving better nutrition. “Food is...
Leaders, Innovators, And Lifelong Advocates: ASTA Recognizes Excellence In Seed
The American Seed Trade Association honored industry pioneers during the 2025 ASTA Leadership Summit, which took place in Washington, D.C., June 8 – 11, 2025. Awardees were recognized in the following categories: Heritage, Distinguished Service, Lifetime Honorary...